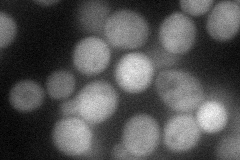
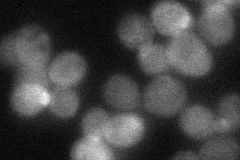

View description
GTPase-activating protein for Gpa1p, regulates desensitization to alpha factor pheromone; also required to prevent receptor-independent signaling of the mating pathway; member of the RGS (regulator of G-protein signaling) family
Localization:
Intensity:
Fold change:
Significance:
-
C’ GFP library in SD

cytosol27.82 -
N' NOP1pr-GFP in SD

cytosol81.5126 -
N' TEF2pr-mCherry in SD
cytosol69.9529 -
N' NATIVEpr-GFP in SD
cytosol,bud neck36.3892 -
N' TEF2pr-VC and Cyto-VN in SD

#N/A0 -
C’ GFP library in SD+DTT

cytosol20.240.72No -
C’ GFP library in SD+H2O2

cytosol26.60.95No -
C’ GFP library in Starvation Media

cytosol16.780.6No -
C’ GFP library on the background of Pup2-DaMP

cytosol -
C’ GFP library on the background of CCT mutant

cytosol24.12770.867039No
